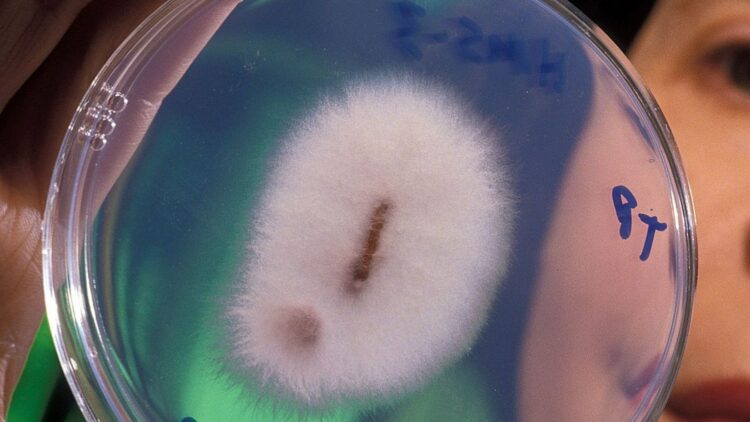
Scientists discover a type of fungus capable of extracting gold - it changes everything 1 Scientists discover a type of fungus capable of extracting gold - it changes everything

If we told you right away that there’s gold being extracted by microscopic fungi that actually grow it, you’d probably scroll past thinking it’s the biggest lie of the day, right? Well, what once sounded like a scientific oddity is now becoming the trending topic in research circles. In Boddington, south of Perth (Australia), a team of researchers has discovered that certain strains of the fungus Fusarium oxysporum can extract gold from their surroundings and metabolize it into their structure.
This discovery, backed by publications like Nature Communications, opens the door to a future where biotechnology could replace the traditional, destructive mining techniques we’re used to.
A very special fungus
Fungi have been helping nature for centuries by breaking down organic waste (like fallen leaves) and participating in the cycles of metals like iron or calcium. But until now, no one had seen them interact with gold, a metal long considered untouchable by these organisms. Until now.
Gold is quite inert in chemical terms, so for researchers like Tsing Bohu, the discovery came as a real surprise. It was so unexpected that he decided to publish it as the first solid evidence that fungi can actively participate in the gold cycle.
The golden mushroom
The CSIRO team in Australia found that these fungi not only interact with gold, they actually grow better when they do. And of course, the industry perked up the moment the news broke.
Australia is the second-largest gold producer in the world, so the team quickly began exploring whether these fungi could be as useful as forests or termite mounds, which are already known to have some connection with gold. They focused on hunting down those golden strains of Fusarium oxysporum.
How would this even work?
We’re talking about something Eduardo Bazo has already coined as “metabolic mining”, in other words, using living organisms to extract gold. And if you’re wondering why… well, you know ambition knows no limits, and now some are looking even farther: beyond Earth.
Gold in space??
Yep, the Solar System has been a target for precious metal hunters for decades. Many have dreamed of exploring it, but beyond technological limitations, we have to add the complexity and risk of handling precious materials… in space!
So, how would it work?
The idea is to genetically modify these fungi to process minerals for us. And even if that sounds super weird and straight out of a sci-fi movie, it might just be the future of mining.
And could it help us down here on Earth?
Traditional mining causes massive pollution: toxic rivers, destroyed landscapes, and absurd energy use. But if fungi can help extract metals like gold, copper, or lithium without digging up the planet, we could totally change the game and finally have a more eco-friendly form of mining.
So if it works, we could even adapt these fungi to survive in extreme conditions!
What sounds like madness today might become our tomorrow. Maybe someday we’ll look up at the sky and think, there are fungi up there.